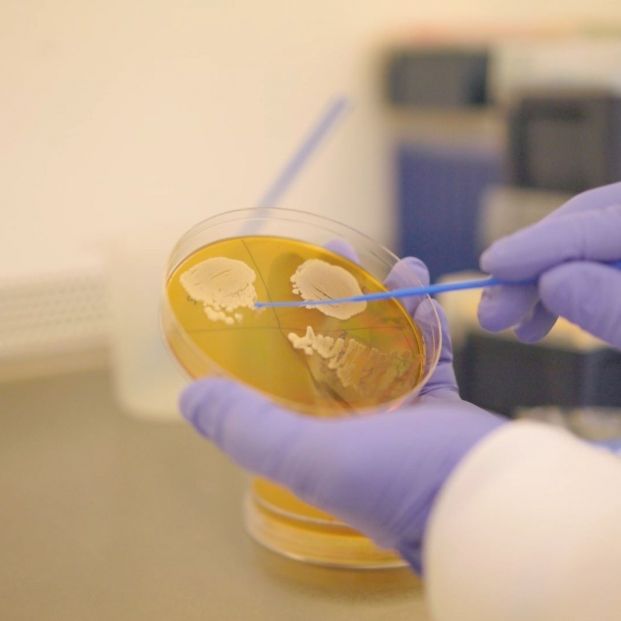
EuropaPress 5406031 investigador selecciona colonia levadura placa agar

La clave para para envejecer mejor está en una dieta saludable desde joven
Así lo han comprobado un grupo de investigadores de la Universidad de Cambridge
Descubir qué debemos hacer para envejecer mejor es la búsqueda del Santo Grial de los últimos años. Investigadores del Instituto Babraham, de la Universidad de Cambridge (Reino Unido), han realizado estudios con levaduras que demuestran que puede conseguirse un envejecimiento saludable optimizando la dieta, si los cambios se realizan en una fase temprana de la vida, según publican en la revista PLoS Biology.
Los experimentos del doctor Jon Houseley y su equipo demuestran que se puede conseguir un envejecimiento saludable mediante cambios en la dieta sin restricciones, optimizando potencialmente la alimentación, y que la mala salud no es una parte inevitable del proceso de envejecimiento.
Los científicos saben desde hace tiempo que la restricción calórica –consumir intencionadamente muchas menos calorías de lo normal sin llegar a la desnutrición– mejora la salud en edades avanzadas e incluso puede alargar la vida. Sin embargo, estudios realizados en ratones demuestran que la restricción calórica debe mantenerse durante toda la vida para conseguir este efecto, y que los beneficios para la salud desaparecen cuando se reanuda una dieta normal.
Ahora, la nueva investigación del doctor Houseley, realizada en levaduras, sugiere que una alternativa a la restricción calórica puede mejorar la salud a lo largo de toda la vida. "Demostramos que la dieta en los primeros años de vida puede llevar a la levadura a una trayectoria más saludable. Al dar a la levadura una dieta diferente sin restringir las calorías, pudimos suprimir la senescencia, cuando las células dejan de dividirse, y la pérdida de forma física en las células envejecidas", afirma la doctora Dorottya Horkai, investigadora principal del estudio.
En lugar de cultivar la levadura con su dieta habitual rica en glucosa, los investigadores cambiaron la dieta por galactosa y observaron que no se producían muchos de los cambios moleculares que normalmente acompañan al envejecimiento. Las células cultivadas con galactosa se mantuvieron tan sanas como las jóvenes, incluso a una edad avanzada, a pesar de no vivir más, lo que demuestra que el periodo de mala salud hacia el final de la vida se redujo drásticamente.
"Crucialmente, el cambio dietético sólo funciona cuando las células son jóvenes, y en realidad la dieta hace poca diferencia en la levadura vieja. Es difícil traducir lo que significa la juventud entre la levadura y los humanos, pero todos estos estudios apuntan a la misma tendencia: para vivir una vida larga y sana, una dieta saludable desde una edad temprana marca la diferencia", explica Houseley.
Las levaduras son buenos organismos modelo para estudiar el envejecimiento, ya que comparten muchos de los mecanismos celulares de animales y humanos. Según señalan los autores, esta vía de investigación en levaduras ayuda a buscar una forma más factible de mejorar el envejecimiento saludable a través de la dieta en comparación con la restricción calórica severa y sostenida, aunque es necesario seguir investigando.
